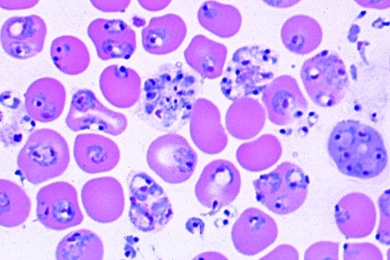
Mikropräparat - Plasmodium, Erreger der Malaria, versch. Stadien im Blutausstrich

Verifizierter Kauf *
Geschrieben von verifizierten Kunden am 04.05.2017
Guter Service
Netter Kontakt
Verifizierter Kauf *
Geschrieben von verifizierten Kunden am 21.01.2016
ausgezeichnete Qualität
Der Einkauf hier hat sich gelohnt
Verifizierter Kauf *
Geschrieben von verifizierten Kunden am 13.11.2012
Gute Qualität rundum
Darum definitiv klare Empfehlung
Verifizierter Kauf *
Geschrieben von verifizierten Kunden am 01.09.2011
alles gute Qualität
Einfache Handhabung, super Qualität.
Herstellerkennzeichnung
Herstellerkennzeichnung
Name: Johannes Lieder GmbH & Co. KGPostleitzahl: Ludwigsburg
Telefonnummer: +49 7141 921919